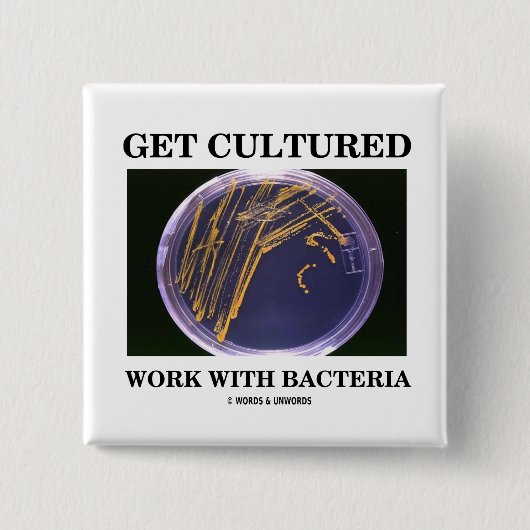
得て下さい細菌(寒天培地)を培養された使用を 缶バッジ (正面)

缶バッジについて
販売:
このデザインについて
得て下さい細菌(寒天培地)を培養された使用を 缶バッジ
"細菌を培養された使用を"得なさいことを言っている科学的な公理と共に寒天培地の細菌を特色にするこれらのギフトの何れかのあなたの歪んだ細菌のユーモアを展示して下さい。 言うこの二重entendreを理解する人類学者または生物学者がある必要性無し細菌文化を含みます!
自動翻訳
カスタマーレビュー
5つ星評価のうち星4.6全レビュー数 29
レビュー:29
類似商品のレビュー
5つ星評価のうち星4
Teito T.2017年12月29日 • 認証済みのご注文
ラウンド缶バッジ, 標準、5.715cm
クリエイターレビュー
イメージ画像のほぼ見た目の通りです。(イメージ画像では少しマットな印象を受ける方もいるかも知れませんが、光沢のある一般的な缶バッジの質感です)
また、標準の5.715cmは、日本で最もよく見かける缶バッジのサイズよりも大きいです。
一度にたくさん頼んだのですが、簡易包装で長距離輸送だったせいか、少し凹みやキズなどがあったものもありましたが、許容できない程ではありませんでした。 ズレなどの問題はこれと言ってなく、満足できました。
5つ星評価のうち星5
DEGU888 R.2019年4月24日 • 認証済みのご注文
ラウンド缶バッジ, 標準、5.715cm
クリエイターレビュー
おすすめします。かわいいDEGU缶バッジ。
サイズも選べてカスタマイズできる。
カラーも豊富。
デグーグッズはzazzleで買える!
国際郵便、問題なく届きます。
スムーズそして、割引カード付き。 とにかく、かわいい。
光沢があります。
マットな素材もほしい。
5つ星評価のうち星5
S.2022年3月7日 • 認証済みのご注文
ラウンド缶バッジ, 標準、5.715cm
Zazzleレビュープログラム
通勤用の鞄に取り付けるのに丁度良いと思いました。 光沢があり、シャープで、塗料がしっかり乗っていて、とても良いです。
タグ
その他の情報
商品 ID: 145854622520450457
出品日: 2011/3/30 6:58
レーティング: G
最近閲覧された商品